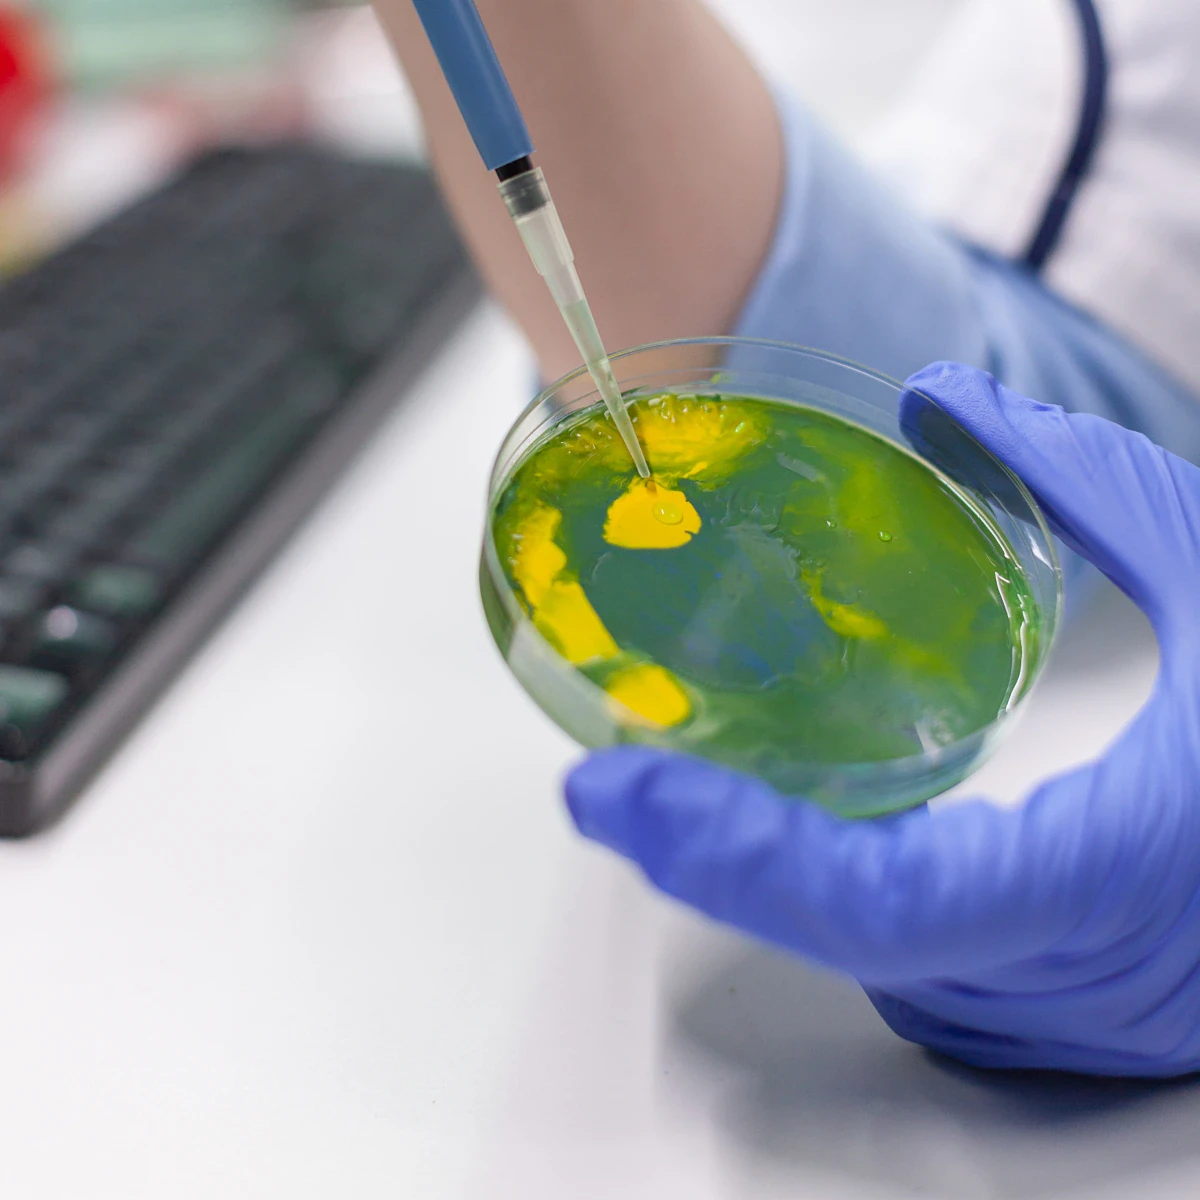

ธุรกิจวิจัยและพัฒนา
จากพลังงานสู่การสร้างสรรค์นวัตกรรมอย่างไม่สิ้นสุด
บริษัทได้จัดตั้งบริษัทย่อยเพื่อดำเนินงานด้านการวิจัยและพัฒนาผลิตภัณฑ์ที่เกี่ยวข้องกับน้ำมันปาล์ม แบตเตอรี่ลิเทียมไอออน และยานยนต์ไฟฟ้า ครอบคลุมทั้งรถยนต์ไฟฟ้า เรือไฟฟ้า และหัวรถจักรพลังงานแบตเตอรี่ โดยมีเป้าหมายเพื่อต่อยอดการพัฒนาไปสู่การเปิดตัวผลิตภัณฑ์นวัตกรรมใหม่ ยกระดับศักยภาพและคุณภาพของผลิตภัณฑ์ที่มีอยู่เดิม และเสริมสร้างความสามารถในการแข่งขันของกลุ่มบริษัทบนพื้นฐานของการเติบโตอย่างยั่งยืนในระยะยาว



ด้านนวัตกรรมชีวภาพ
กลุ่มบริษัทมุ่งเน้นการวิจัยและพัฒนาด้านนวัตกรรมชีวภาพ เพื่อยกระดับและเพิ่มมูลค่าสินค้าเกษตรไทย โดยเฉพาะจากวัตถุดิบปาล์มนำไปต่อยอดเป็นผลิตภัณฑ์หรือบริการที่สร้างมูลค่าเพิ่มให้กับกลุ่มบริษัทในเครือ ผลงานวิจัยสนับสนุนการพัฒนาในกลุ่มผลิตภัณฑ์ เช่น กรีนดีเซล, สารเปลี่ยนสถานะชีวภาพ (Bio-PCM) และน้ำมันเชื้อเพลิงอากาศยานแบบยั่งยืน (Sustainable Aviation Fuel: SAF)
ดำเนินการโดย: บริษัท กรีน เทคโนโลยี รีเสิร์ช จำกัด

ด้านยานยนต์ไฟฟ้า
กลุ่มบริษัทมุ่งเน้นการวิจัยและพัฒนาเทคโนโลยียานยนต์ไฟฟ้าแบบครบวงจร ครอบคลุมทั้งรถยนต์ไฟฟ้าเชิงพาณิชย์, เรือโดยสารไฟฟ้า, หัวรถจักรไฟฟ้า, ระบบแบตเตอรี่ และระบบที่เกี่ยวข้อง เพื่อสร้างสรรค์นวัตกรรมที่ตอบโจทย์ความต้องการของตลาด การดำเนินงานอยู่ภายใต้แนวคิด “MISSION NO EMISSION” พร้อมจัดตั้งศูนย์วิจัยยานยนต์ไฟฟ้าเชิงพาณิชย์ในชื่อ “MINE Mobility” เพื่อเป็นฐานพัฒนานวัตกรรมยานยนต์ไฟฟ้าเชิงพาณิชย์ของคนไทยอย่างยั่งยืน
ดำเนินการโดย: บริษัท ไมน์ โมบิลิตี รีเสิร์ช จำกัด


ด้านแบตเตอรี่
กลุ่มบริษัทมีเป้าหมายในการพัฒนาเป็นศูนย์กลางการทดสอบแบตเตอรี่ระดับนานาชาติ ครอบคลุมการทดสอบแบตเตอรี่ในขนาดต่างๆ และการใช้งานในผลิตภัณฑ์หลากหลายประเภท ศูนย์ทดสอบแห่งนี้ติดตั้งเครื่องจักรและอุปกรณ์ที่ใช้เทคโนโลยีขั้นสูง รองรับการทดสอบตามมาตรฐานสากล
ดำเนินการโดย: บริษัท ศูนย์ทดสอบแบตเตอรี่ ยานยนต์ไฟฟ้า และผลิตภัณฑ์อิเล็กทรอนิกส์ จำกัด (BEV)

